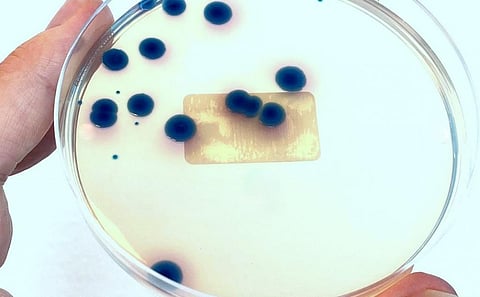

Antimicrobial resistance: 5 years after AMR national plan came out, only 3 states have one of their own
Carbapenem-resistant Klebsiella. Photo: iStock
The Global Action Plan on Anti Microbial Resistance (GAP AMR) was declared by World Health Organization (WHO) in 2015. India launched its National Action Plan on AMR (NAP AMR) in 2017.
Health being a matter of individual states, all Indian states and Union Territories (UT) were advised to develop their respective State Action Plans (SAP) within the framework of NAP AMR. Time and again, it has been advocated to develop the AMR action plans holistically with the concept of One Health.
After five years of NAP AMR, it is time to look back and assess it and the various SAPs through the lens of One Health.
There were only three states that had come up with their SAP on AMR by November 18, when the World Antibiotic Awareness Week 2022 began. Kerala was the first of these. It developed the Kerala Antimicrobial Resistance Strategic Action Plan or KARSAP in October 2018.
Madhya Pradesh was the second state to declare its Action Plan in July 2019 (Madhya Pradesh State Action Plan for Containment of Antimicrobial Resistance or MP-SAPCAR).
Delhi was the third state to develop its SAP (State Action Plan to Combat Antimicrobial Resistance in Delhi or SAPCARD) in Jan 2020. None of the other states or UTs have their SAP ready as of today.
The Indian Council of Medical Research-initiated Anti Microbial Resistance Surveillance Network mentions Carbapenem (one of the highest generation of antibiotics) susceptibility of E. coli has dropped steadily to 64 per cent in 2021, from 86 per cent in 2016.
The susceptibility of Klebsiella pneumoniae has dropped steadily to 43 per cent for the year 2021, from 65 per cent in 2016.
Though most of these data have been contributed by tertiary care institutes, it is shocking to imagine the corresponding AMR in the community. Being an infectious disease clinician and active in this field for more than a decade now, I strongly believe this dreaded trend will be similar at community-level in primary and secondary healthcare delivery centres also.
India is a large country with 28 states and eight UTs. Hence, it is shocking to know that only three states have some sort of action plan in place.
The question that naturally arises is whether India is committed enough to combat AMR. The NAP AMR-2017 has revolved around human health and at tertiary care centres.
When the framework itself has no distinct component of Community level Anti Microbial Stewardship (Community AMS), it is imperative that the SAPs will also be reflective of that framework.
Analysing each of the three SAPs through the lens of One Health, it seems there are only passing remarks about inter-sectoral action plans with measurable outcomes.
Kerala is the best among the three. The states of Madhya Pradesh and Delhi also recognise animal health, agriculture, fishery and environment as collaborating partners to human health in the fight against AMR.
In the fifth year of declaration of NAP AMR, the time has come to re-strategise our priorities with a holistic One Health approach. Nurses, paramedics, animal health practitioners, environmentalists, food and soil scientists should be regular features in all AMR initiatives.
As a matter of policy, we have to develop generations of animal health practitioners, agriculture, food, soil and environmental scientists equipped with solutions to AMR or rather the mindset of tackling the unseen enemy of AMR.
Till that time, the AMR campaign will remain an armchair campaign for elite practitioners of human health.
Sagar Khadanga is Nodal Officer, Technical Committee, Madhya Pradesh State Action Plan on AMR
Views expressed are the author’s own and don’t necessarily reflect those of Down To Earth